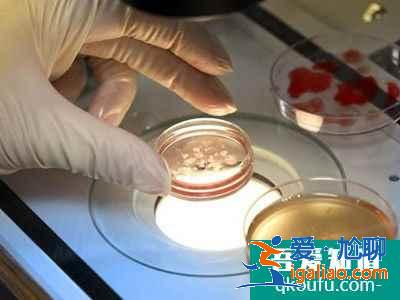

做試管嬰兒前應做哪些心理準備??
心理這個問題是最難干預的。很多人來最后來到做試管嬰兒這個步驟的時候,都已經是經歷了很漫長的備孕,或者說助孕的一些掙扎,或者治療。他可能心理上是有很多的隱性的一些困擾,或者甚至有輕度的抑郁。甚至有一些患者都抑郁癥,那么心理干預也是我們試管嬰兒這個輔助生殖團隊很關注的一點。

1做試管嬰兒前應做哪些心理準備?
有一些比較重要的崗位上,還會有心理咨詢治療師。大的中心,可能都會有這一些。或者是跟心理科、精神科聯合。建議他們做一些助孕前的心理的一些疏導。但是哪怕做了咨詢,還是有很多患者會處于一個高度緊張的狀態,這個也是難免的。畢竟你對它的成功率以及它相應產生的時間、經濟的成本都會給你造成壓力。所以我們很難非常有效的讓患者不要緊張,或者說放松下來。

Tips
但是不管怎么說,我相信我們還是會建議,如果這一對夫妻要做試管嬰兒,你們盡量的把心情放輕松,然后抱著一種努力,然后又是信任的態度跟醫生進行交流跟溝通。我想所有的醫護人員都會愿意盡最大的努力來幫助你們。
2做試管嬰兒前需要檢查哪些項目?
做試管嬰兒前需要檢查項目可能一一列舉太多了。我大概把它總結一下,會分為以下這些:
男方跟女方都要查。那么這個檢查包括對于一個女性身體健康狀態的評估,她是否有一些不利于妊娠的一些禁忌證,這個是大前提。如果一個女生本身就不健康,她就不適合去給她有計劃的去備孕。尤其是試管嬰兒,后續還有很多費用的產生。所以這是一個很重要的篩查。
第二個,很重要的一個對女性檢查就是卵巢功能的評估。
也是我們決定試管嬰兒成敗的重要的環節。也就是說如果從評估上我們臨床醫生可以初步有一個判斷。這個女性在這個周期中,大約她的可能給到的卵子數是多少。那卵子的數量也直接決定了最后的一個成功的結局。所以這個評估是 卵巢功能的評估是非常重要的。
還有一些就是對于身份信息相關的一些確認。比如說血型,這個是雙方必須要做的。因為我們試管嬰兒的很多重要的步驟都是在實驗室,而且可能一天不止一對夫妻在做。所以這個身份信息的核查、相應的染色體、以及這個血型的這些檢查都是非常重要的。
男方的話,除了剛才講到的身份。還有對他生育力的 比如說精液。女方是卵子,卵巢功能。那么男方就是精液質量的評估。我們也可以說,大概可以預測男性因素,在這一次治療中間有沒有一些不利的一些因素的影響。然后再還有就是傳染病相關的。
Tips
因為男性很重要的,他的傳染性感染,疾病感染性疾病可能會包括女方也一樣,他可能會導致一個交叉感染的風險。所以這些像肝炎、梅毒、艾滋病等等這類的感染性疾病的篩查也是重要的一部分。
3影響試管嬰兒成功的因素有哪些?
大家都知道試管嬰兒是一個綜合的學科,它包括臨床、實驗室、遺傳等等。
那么影響試管嬰兒成功的因素有哪些呢?
所有的因素里面最重要的是女性的年齡。我們常言說年齡,就是說女方的年齡是非常重要的。精子也很重要,精子質量質量也影響試管嬰兒的結果。綜合起來是婦女和男方雙方都對試管嬰兒的結局有很大的影響。當然,臨床醫生的技術,實驗室的技術也對臨床的結果有直接的影響。
試管嬰兒所有的過程都很重要,<愛尬聊_生活百科>每一個過程不小心不注意都會影響試管嬰兒的結局。
我們在臨床上要綜合考慮病人的實際情況,采取不同的治療手段,排除所有的影響因素,這樣才能提高試管嬰兒的成功率。所以在這里請大家不要強調某一點。

Tips
影響試管嬰兒成功率的因素是綜合性的,所以大家一定要考慮到試管嬰兒,它有男方的因素,有女方的因素,也有醫生的因素,也有實驗室的因素,它是一個綜合的一個技術。它對各個步驟都有很高的要求。
